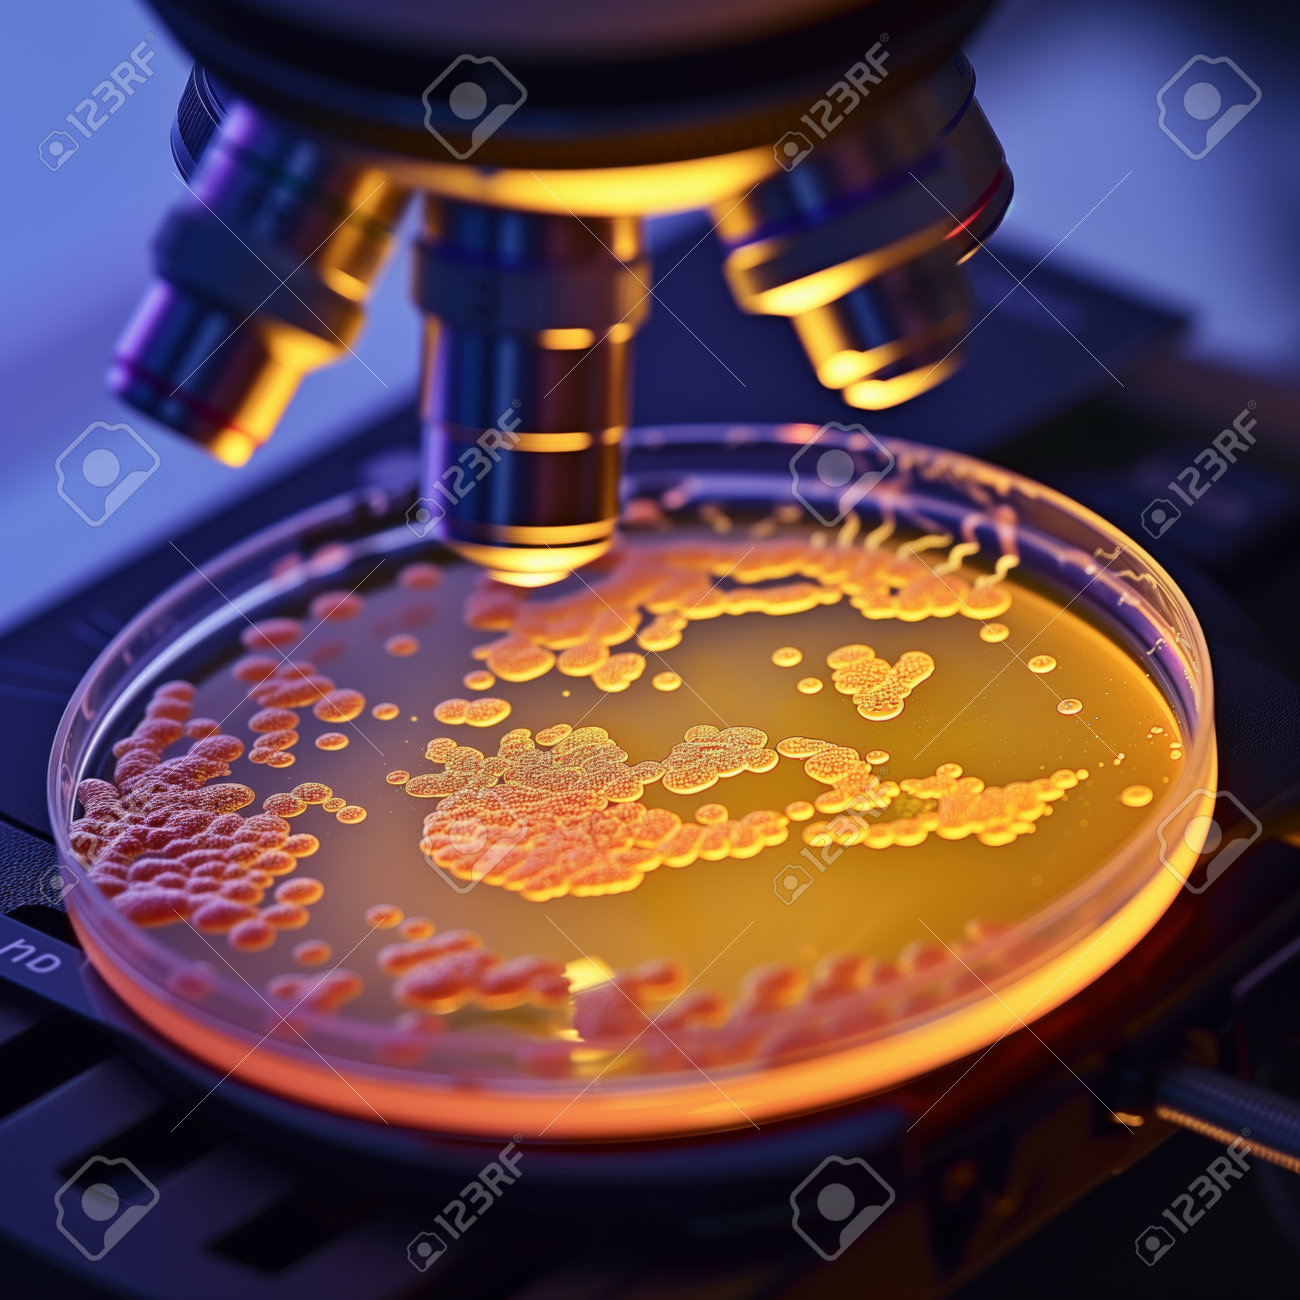
etiam-dictum-ipsum-a-felis

Download
Close
Автор:
id:
Ключевые слова:
agar, ai, ai generated, analysis, bacteria, biochemistry, biological, biotech, biotechnology, clinical, closeup, colonies, cultivation, culture, disease, dish, equipment, experiment, glassware, growth, health, illuminated, incubation, investigation, lab, laboratory, lens, macro, magnification, medical, microbiology, microorganism, microscope, observation, optics, organism, pathogen, petri, pharmaceutical, plate, research, science, scientific, specimen, sterile, study, yellow,





